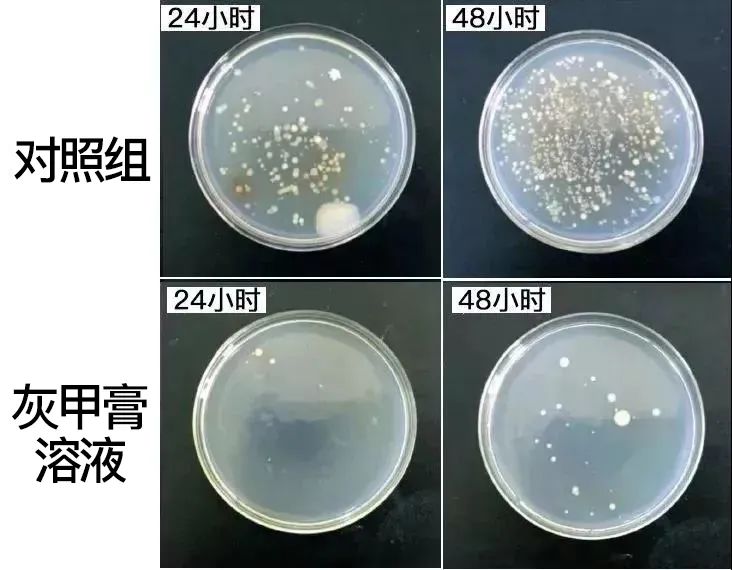
图片

有调查显示,每10个人当中就有一个人患有灰指甲!

很不幸,我朋友就是其中之一!
刚开始她没有注意到问题的严重性,只是发现指甲越长越难看,越长越畸形……
后来才意识到是长了灰指甲,她开始变得尴尬,开始缩手缩脚……灰指甲的痛,经历过的人才懂。

灰指甲的学名叫甲藓,本质是由于真菌引起的指甲感染。

▲图片来源于百度健康医典
而一旦染上,就会引起指甲变色、变薄、变碎或畸形,主要表现为凹凸不平、长有白斑、变厚、浑浊.......

不仅影响美观,还会给生活带来巨大影响。
灰指甲就是“社交杀手”,交际时不敢握手、约会羞于牵手,夏天也不好意思穿凉鞋、拖鞋。
想象一下,你在生活中见到手指灰黑的人,一定不敢伸出手去握,或者握完了,也一定要立马用洗手液、酒精消毒个好几遍吧~

当然最可怕的还是“得了灰指甲,一个传染俩”,不仅在自己的手脚指甲上传染,还容易传染给家里的老人和小孩!
严重的可能引发并发症(如嵌甲、丹du、体股藓等)甚至会危害生命!

为了避免传染给家人,得了灰指甲就要格外注意:
1、毛巾、脸盆、水桶要和家人分开用;
2、不能触碰洗干净的餐具和衣物;
3、家里有小宝宝的,抱一抱时必须要戴手套。
是不是瞬间觉得人间不值得,而且长此以往,还会使人患有抑郁情绪。

大人已经无法忍受,更何况是孩子?
如果家里的孩子染上了灰指甲,他可能就会遭受同学们的嫌弃和孤立,更容易造成心理压力过大!
从而影响到学习成绩,要是孩子再“想不开”,留下童年阴影就糟了!

很多人就像我朋友一样,染上灰指甲后,觉得不痛不痒,以为它会自己慢慢变好,结果越拖越严重!
所以,一旦感染灰指甲,应当及时进行干预,夏季不用经常把脚闷在鞋子里,正是对付灰指甲的好时机。

但是,跟灰指甲斗争过的人都知道,它是有多顽固多难治!
古方土方泡、包,甚至是刀片割、拔指甲......罪受了那么多,最后还是无济于事,长出来的指甲还是老样子,而且费用动不动就是成百上千!


好在科技的进步是不但造福于人民的,今天就给大家推荐这款“拯救灰指甲”——「九福堂本草皮肤抑菌膏」

因为效果好,我们都叫它「灰甲膏」,早晚一次,不用包,不拔甲,快速吸收,早早告别灰指甲,长出“亮甲”!

这还是在医学院读博的姐姐推荐给我朋友的,我朋友3个月,每天坚持涂抹使用,慢慢地老甲逐渐脱落,到现在已经长出了圆润规则的健康新甲!

真真是灰指甲的“克星”了,这款灰甲膏自从上市以来,已经帮助上万人解决了灰指甲难题!
不管是甲脱落、甲分离、甲淤血、甲凹凸、甲发黄、甲增厚,还是甲萎缩,改善效果都非常地明显和见效!

终结灰甲,戳图抢购▼

循序渐进
科学解决灰指甲
在介绍产品之前,必须说一下好多人陷入的误区哦!
因为有太多人沉迷于小广告,在网上胡乱买了很多相关产品,使用之后却发现收效甚微,甚至还由此打击了解决灰指甲的信心。

但有效的改善一定是立足于科学基础之上的。人的指甲平均的长度为16mm,生长速度是每天0.1㎜,完全长新甲大约是5个月左右!

那些不知名的网络功效产品,通过夸张的宣传,扬言“7天、14天就能长出新指甲!”
真是吹牛都不打草稿,站着说话不腰疼,活生生把我们消费者当傻子糊弄!

九福堂的这款灰甲膏可“做不到”,因为这完全脱离了科学实际!

这款产品能做的是循序渐进地改善,虽然较慢,但效果好,最终让你的灰指甲脱落,逐渐长出健康新指甲。

而它整个过程也需要经历四个阶段:
先减少病痛停止恶化;
持续使用杀灭真菌;
修护受损后的甲床;
最终生长出健康的新指甲。


受益人一:王女士;白领;甲凹凸、甲发黄

我的脚特别会流汗,因为工作原因,夏天也不能穿凉鞋,去年得了灰指甲。起初只是指甲凹凸不平,到后来变黄变黑,怪吓人的,洗脚店都不敢去了。
这个灰甲膏是同事推荐的,他的灰指甲就是靠这个解决的。
用了差不多一个月的颜色就变淡了,凹凸不平的情况也改善许多,三个月的时候,慢慢长出来的新指甲,就是健康的了,真的蛮惊喜的。
受益人二:圆圆;主妇;甲增厚,甲分离

身边的小姐妹,有空就会约起来去逛街,做做美甲,谁知道灰指甲找上门了,哦哟这丑的谁受得了啊!
还好有个姐妹的老公是医院手足科的,说这个灰甲膏靠谱,涂在指缝、甲床上面,涂抹后就行,原来的旧甲慢慢剪掉后,长出来的指甲和食指就和健康的指甲一样。
受益人三:徐先生;退休;甲增厚,甲黑黄

灰指甲拖了好几年了,长出来的指甲都是黄色的,每次去看孙女都讨人嫌,产品用了一堆,土方子也试了,就是没效果。
这款灰甲膏是儿子给我买的,效果竟然这么明显,灰指甲慢慢剪掉后,新长出来的指甲都是肉色的。现在灰指甲好了,孙女跟我都亲近了。

根源清除真菌
效果好不反弹
在解决灰指甲之前,我们首先要弄明白,灰指甲到底是怎么来的?
它是由于真菌感染引起的。
虽然指甲很坚硬,但如果患有脚气,常穿不透气的鞋,或者免疫力受损,真菌就很容易入侵。

例如:如果你有脚气(手足藓),还常穿不透气的鞋,真菌就有可能感染到脚趾甲里面。
如果你习惯用指甲去抓脚,就很容易将真菌带到手指甲里,从而手指甲也感染成灰指甲。

所以对付灰指甲,其实就是杀灭真菌的过程,杀灭真菌,清理残留,才能根本上避免灰指甲反复。

这款灰甲膏添加的是国家卫生部公认的抗菌杀毒成分:「醋酸氯已定」。

有效渗透病甲,快准狠对菌群进行绞杀击溃,恢复甲床细胞生机活性,筑起健康基地。

为了「测试效果」,我们还特意做了实验验证:
在真菌培养皿里面倒入这款灰甲膏溶液,分别查看24H、48H,对照组已被菌落占领,而倒入灰甲膏溶液的培养皿,只有零星几点菌体。
不同于某些有刺激性的灰甲产品,这款灰甲膏是不含任何ji素成分的。
它在推出时已经获得「国家权威消毒产品安全评估报告认可」,实打实安全有效!

可以避免一些药用的刺激依赖,真菌杀灭的不彻底导致的反复问题。
其实我们的身体恢复能力也是很强的,只要你给指甲一个干净的环境,它就可以很快长出健康的指甲来。

有这支灰甲膏的守护,再也不怕灰甲带来的丑陋和尴尬,职场工作、结识新朋友,指甲干净整洁,握手更自信!

拥有一双优雅美丽的手,和恋人约会时,牵手更大胆!

公共浴室、泳池、沙滩,露脚不担心,脱鞋更自然,夏天出门脱鞋、凉鞋肆意穿!


成分安心不刺激
坚持用就能重获美甲
这款灰甲膏使用起来是没有任何副作用的,比起市面上普通灰指甲液,成分安全温和,适合多种人群,使用安全性高!

而且各种成分的用量,都是经过科学实验配比出来的,对皮肤没有刺激性,不伤肤。
我们还进行了PH测试,PH数值为5-6呈弱酸性,接近人体的酸碱环境,直接涂在指甲缝里也很安心。

用起来就像抹护肤霜一样方便,挤出一点在指甲上均匀抹开,不用包甲,不脏袜子,也不影响走路,特别方便。

坚持使用就有可能,就能让指甲恢复健康!

每一支灰甲膏都符合质量检测标准,原材料的选取、运输、清洗、加工、萃取,都有专人把控,以保成分品质和功效。
每一批货都有拿到第三方质检机构进行严格检测,各项指标符合国家标准,才会送到消费者手上。

1支20g,能用1个月左右,根据一天2次的用量估算,用到告别灰指甲,大概需要4-5支(推荐使用5支巩固更佳),而且更划算!

灰指甲不是不能解决,只是不能急功近利,找对方法,用对产品,坚持使用,一定有用!

给我们的指甲一点时间,它虽然得了病,但是通过内外兼施的抑菌修护,它会变好。
注意预防,坚持干预,不久后,又是一双好手好脚。

我们还为有需要的粉丝争取了福利价:
日常价79.9元/支
现在下单一支只要49.9元
买2送1,3支只要89.8元!
买3送2,5支只要129.7元!
买5送4,9支只要199.5元!
9支平均一支算下来只要22块钱!
本平台所购产品均为正品,每盒包装上都有防伪码可查,可以放心购买。
